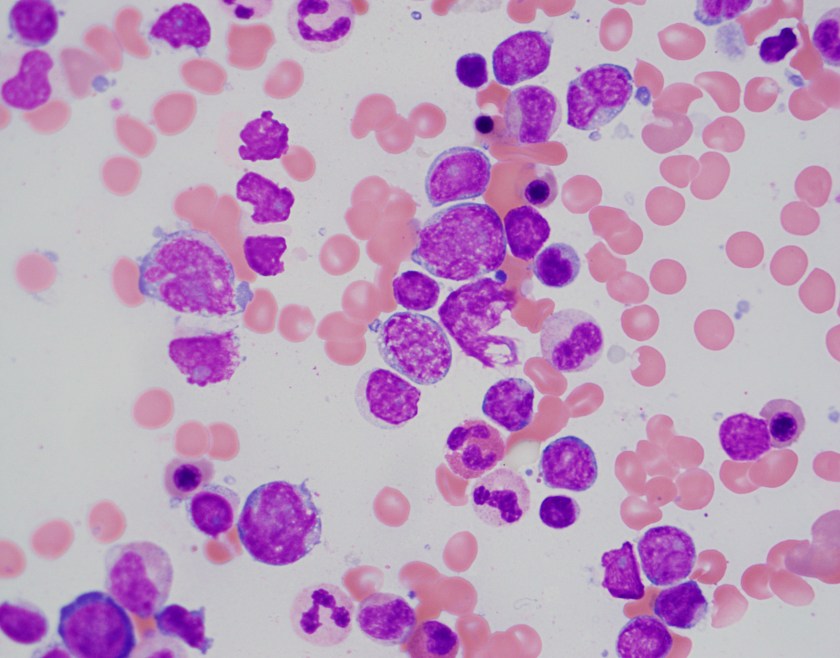
mcl-bm-40

In today’s clinical laboratories there are an increasing number of tests available for physicians to order. In a constant effort to provide the best tools for patient care, laboratories typically issue a Laboratory Technical Bulletin when new platforms or new testing is available. These help introduce physicians to or update them on the ever changing array of test availability. In Hematology, Advanced Clinical Parameters are an extension of the traditional CBC and Automated Differential. Used appropriately, these new tests can provide a wealth of knowledge that can be available to physicians in making diagnoses. In my July post, (Beyond the CBC and Reticulocyte Count: Early Detection of Iron Deficiency Anemia), I discussed the Reticulocyte Hemoglobin (RetHe) and it’s uses in early detection and better management of iron deficiency anemia. In this blog I will explore the Immature Granulocyte Count (IG%), another of the Advanced Clinical Parameters.
Historically, the 100 cell manual differential has been used to enumerate percentages of each cell type present and to detect the presence of abnormal cells, including immature granulocytes. An increase in band count >10 %, was, and is still often used with other screening tests as an indicator of infection or sepsis. The first microscopic image analyzer, the Perkin-Elmer Cellscan in 1966, could recognize neutrophils, lymphocytes and monocytes with 90% accuracy, and a 100 cell differential could be completed overnight. With improved, faster computers this instrument was marketed in the mid 1970’s and then purchased by Coulter Electronics in 1977 to become the Coulter Diff 3. These first hematology analyzers to provide an automated differential yielded a 3 part differential, and then more sophisticated instrumentation gave us the 5 part diff. In the beginning, an automated differential only counted 100-200 cells and manual diffs performed by a trained technologist were still considered superior. Today’s hematology analyzers count over 30,000 cells using impedance and flow cytometry to give us a statistically superior automated differential.
An automated 5 part differential will flag a ‘Left Shift’ when bands are seen. Many laboratories then perform a scan or manual diff. However, bands are very subjective and therefore it has been questioned if the band count is truly useful as a clinical indicator of sepsis. If a band count >10% is an indicator of sepsis, what happens when 2 or 3 technologists perform diffs on the same slide and get a band % range between 5% and 19%? 5% would not indicate sepsis, whereas 19% exceeds the 10% cutoff almost twofold. Two experienced technologists can perform a manual diff on the same slide and get band counts in a fairly wide range depending on their training and which definition of bands they use and which 100 cells they see in their count. On the other hand, a 6 part automated differential counts and differentiates over 30,000 neutrophils, lymphocytes, monocytes, eosinophils, basophils and immature granulocytes. The auto diff separates bands and immature granulocytes. Band cells are considered mature and included in the neutrophil count. The Advanced Clinical Parameter, Immature granulocytes (IG%) include metamyelocytes, myelocytes and promyelocytes. In the peripheral blood these immature granulocytes are an indicator of leukopoiesis, cells just coming out of the bone marrow and represent the earliest information possible and an earlier indication of inflammation and infection than a band count. The example below illustrates this concept.
Case Study 1
A patient admitted to the ER with high fever and chills has a CBC and auto diff ordered. His WBC is elevated and percent neutrophils are high. The physician suspects sepsis despite the normal WBC and orders a CRP and blood cultures. CRP results are within normal limits. The immature granulocyte counts are shown below on admission and in 4 subsequent phlebotomies. Antibiotics were started 3 hours after initial triage. The patient was admitted to the hospital and Streptococcus pneumoniae was isolated from the blood cultures at 48 hours.

The IG% and absolute counts are increased in this patient when other markers of infection are not. An IG% of >1% is indicative of a true left shift and >3% may predict positive blood cultures. The ED can also use the IG to determine that the infection is community acquired and not nosocomial if the IG% is high on admission. Note the band counts here that could be high or low depending on who performed the diff. This demonstrates the inherent subjectivity and imprecision of band counts and manual differential counts because they are done on only 100 cells. The immature granulocyte count is automated, not subjective. In checking the slide for correlation, we see the presence of these immature granulocytes. The IG% is thought to be better as a predictor of sepsis than the WBC and band count. For this reason, with the availability of a 6 part diff, labs have encouraged physicians to order and use the automated differential.
Another application of the utility of the IG% is seen in comparing IG% and ITR, immature to total neutrophil ratio. ITR is used by neonatologists to determine infection. The ITR is a calculation based on a 100 cell manual differential. In this formula, the immature neutrophils are bands, myelos, metas and pros. An ITR <0.2% is a negative predictive value for sepsis.
Immature neutrophils/Total neutrophils=bands+myelos+metas+pros/total neutrophils= ITR
Case Study 2

In 2 babies less than 30 days old, we see again here the phenomenon of a wide variety of bands counted by 2 techs. In the ITR, bands are counted as immature cells. Despite the imprecision of the band count, Baby A has >10% bands counted by both techs and the ITR range is >0.2% in both calculations. However, in Baby B, we see that the band count from one differential was 5% and the second tech counted 17% bands. Since the bands are used to calculate the ITR, one calculation gives an ITR of 0.06%, a negative predictor of infection, and the second count gives an ITR of 0.22%, above the 0.2% threshold. At the same time, if physicians are looking at an absolute neutrophil count(ANC), the number of neutrophils available to fight off infection, this number is calculated using bands and neutrophils. In one formula, bands are lumped with immature cells, and in the other, bands are included with mature cells. This can be confusing information. If we were instead to rely on the automated differential, the IG% gives us a more clear and precise measure of sepsis. Using the previously stated criteria for infection, the IG% of Baby A is clearly above 3% and in Baby B is well below 1%.
How do band counts compare to the IG%? Should bands be eliminated as an indicator of infection? Studies have been done that suggest that the WBC and band counts are not as reliable in predicting infection as the IG% and ANC. Suggestions have been made that the left shift should be redefined with IG% rather than bands. Bands may be too subjective to be the best indicator of infection and they lead to an imprecision in the ITR. The IG count can highlight potential acute infection or inflammation at its earliest stages, even when other parameters are still within normal ranges. IG counts (% and #), reported with the automated differential, reduce turnaround time and are valuable for clinicians to use in conjunction with other current indicators for the diagnosis of infection and inflammation.
References
- Ansari-Lari, M.Ali et al. Immature Granulocyte Measurement Using the Sysmex XE-2100 Relationship to Infection and Sepsis Am. J Clin Pathol. 2003,Nov;120(5):795-9.
- Balamurugan Senthilnayagam, et al. Automated Measurement of Immature Granulocytes: Performance Characteristics and Utility in Routine Clinical Practice. Patholog Res Int. 2012: 483670. Published online 2012 Feb 15. doi: 10.1155/2012/483670
- Cavallazzi, R et al. Is the band count useful in the diagnosis of infection? An accuracy study in critically ill patients. J Intensive Care Med. 2010, Nov-Dec;25(6):353-7.
Dutcher, Thomas F. Automated Leukocyte Differentials: A Review and Prospectus. Laboratory Medicine, Volume 14, Issue 8, 1 August 1983, Pages 483–487, https://doi.org/10.1093/labmed/14.8.483 - McDaniel, Holly. Ban the Bands. Sysmex News, 2013. https://www.sysmex.com/crc/ACP/IG_Ban_the_Bands.pdf
- Sysmex America White Paper. Getting Beyond the Flags: Quantitative assessment of immature granulocyte (IG) populations may improve the assessment of sepsis and inflammation. http://www.sysmex.com/us

-Becky Socha, MS, MLS(ASCP)CM BB CM graduated from Merrimack College in N. Andover, Massachusetts with a BS in Medical Technology and completed her MS in Clinical Laboratory Sciences at the University of Massachusetts, Lowell. She has worked as a Medical Technologist for over 30 years. She’s worked in all areas of the clinical laboratory, but has a special interest in Hematology and Blood Banking. When she’s not busy being a mad scientist, she can be found outside riding her bicycle.